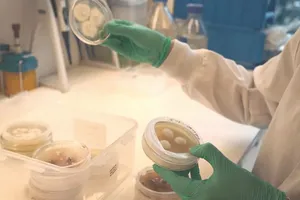
Tạo nguồn thực phẩm cho tương lai

Từ khóa: #nấm sò
có 1 kết quả
© Bản quyền Báo SÀI GÒN GIẢI PHÓNG.
Giấy phép hoạt động Báo in và Báo Điện tử số 305/GP-BTTTT do Bộ Thông tin và Truyền thông cấp ngày 28-8-2023.
Quyền Tổng Biên tập: Nguyễn Khắc Văn
Phó Tổng Biên tập : Nguyễn Ngọc Anh, Phạm Văn Trường, Bùi Thị Hồng Sương, Trương Đức Nghĩa, Lê Minh Tùng
Phó Tổng Thư ký tòa soạn: Nguyễn Chiến Dũng
Tòa soạn : 432-434 Nguyễn Thị Minh Khai, Phường Bàn Cờ, TP.HCM
Điện thoại Báo SGGP: (028) 3.9294.091, 3.9294.092, 3.9294.093, 3.9294.097, 3.9294.098
Điện thoại Tòa soạn Báo Điện tử: 08 65 11 22 55
Liên hệ quảng cáo :